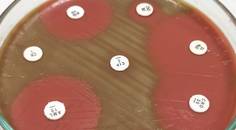

advertisement
Infectious Disease
337-352 of 426
eurekalert.org
02/15/2024- Medical NewsHackensack Meridian Health Biologist-Turned-Med Student Publishes COVID-19 Vaccine Study
bioengineer.org
02/15/2024
news-medical.net
02/15/2024
eurekalert.org
02/15/2024- Medical NewsResearchers Develop Economical Tool to Facilitate Identification of Disease-Causing Pathogens
smu.edu
02/15/2024 - Medical NewsStudy Finds High Levels of Physical Activity Lower Risk of Developing COVID-19 Infection and Hospitalization
medicalxpress.com
02/15/2024
ed.ac.uk
02/15/2024
hopkinsmedicine.org
02/15/2024- Medical NewsResearchers Offer New Insights into How Antibodies Function Against Herpes Simplex Virus
medicalxpress.com
02/13/2024 - Medical NewsRobotic-Assisted Surgery and Navigation Don't Affect Infection Risk After Hip Arthroplasty: Study
medicalxpress.com
02/12/2024
news.gsu.edu
02/09/2024
newsweek.com
02/08/2024
news-medical.net
02/08/2024
lifetechnology.com
02/08/2024
news.cornell.edu
02/08/2024- Medical NewsCARB-X Funds Visby Medical to Develop a Portable Rapid Diagnostic for Gonorrhea Including Antibiotic Susceptibility
eurekalert.org
02/08/2024